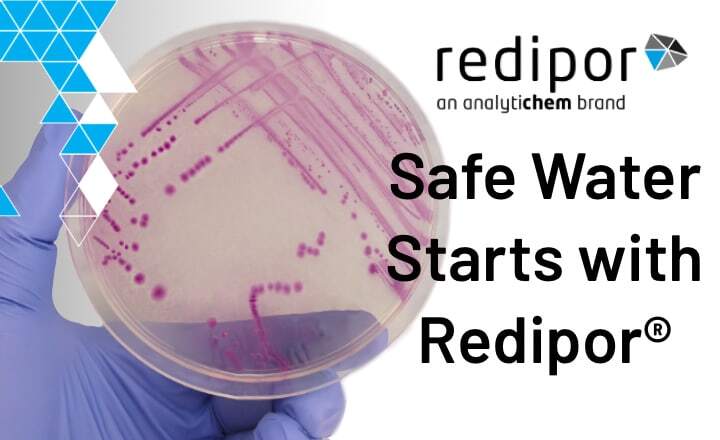
Safe Water Starts with Redipor

Clean, safe water is vital for public health and environmental protection. In Europe and the UK, monitoring programs follow the EU Drinking Water Directive (2020/2184) and national standards. Across drinking water, industrial systems and wastewater monitoring, accurate detection of waterborne pathogens such as total coliforms, faecal coliforms, Salmonella spp, Shigella spp, Legionella pneumophila and Pseudomonas aeruginosa is essential for regulatory compliance and consumer safety.
Redipor, part of the AnalytiChem portfolio, provides dependable, ready-to-use media designed by experts to ensure confidence in every result. There are many reasons why labs choose Redipor when testing for waterborne pathogens:
- Proven reliability: Trusted, high-quality Redipor formulations such as Plate Count Agar, R2A, MacConkey and XLD Agar deliver consistent growth for confident enumeration and identification.
- Longer shelf life: With validated stability of up to 112 days on key media, Redipor products reduce waste, lower costs and support more efficient inventory management compared with other brands.
- Rapid identification: Chromogenic and selective media enable rapid visual identification of target organisms, improving speed and clarity in water testing workflows.
- Flexible, tailored formats: As well as off-the-shelf products, Redipor is available in tailor-made formats, with customisable options such as packaging type, product formulation and batch size available to meet each lab’s unique requirements.
Whether supporting routine water quality monitoring, environmental surveillance, or validation of purification systems or cooling towers, Redipor prepared media combines proven analytical performance with ready-to-use convenience. With each batch manufactured to stringent quality standards to ensure consistency, reliability and reproducible results, Redipor represents a far more efficient and economical solution than producing media in-house.
Test for waterborne pathogens effectively, and safeguard public health with confidence. Explore AnalytiChem’s trusted Redipor range for microbiological water testing solutions, and discover how reliable, consistent media makes every result count.
Learn more about Redipor® water testing solutions